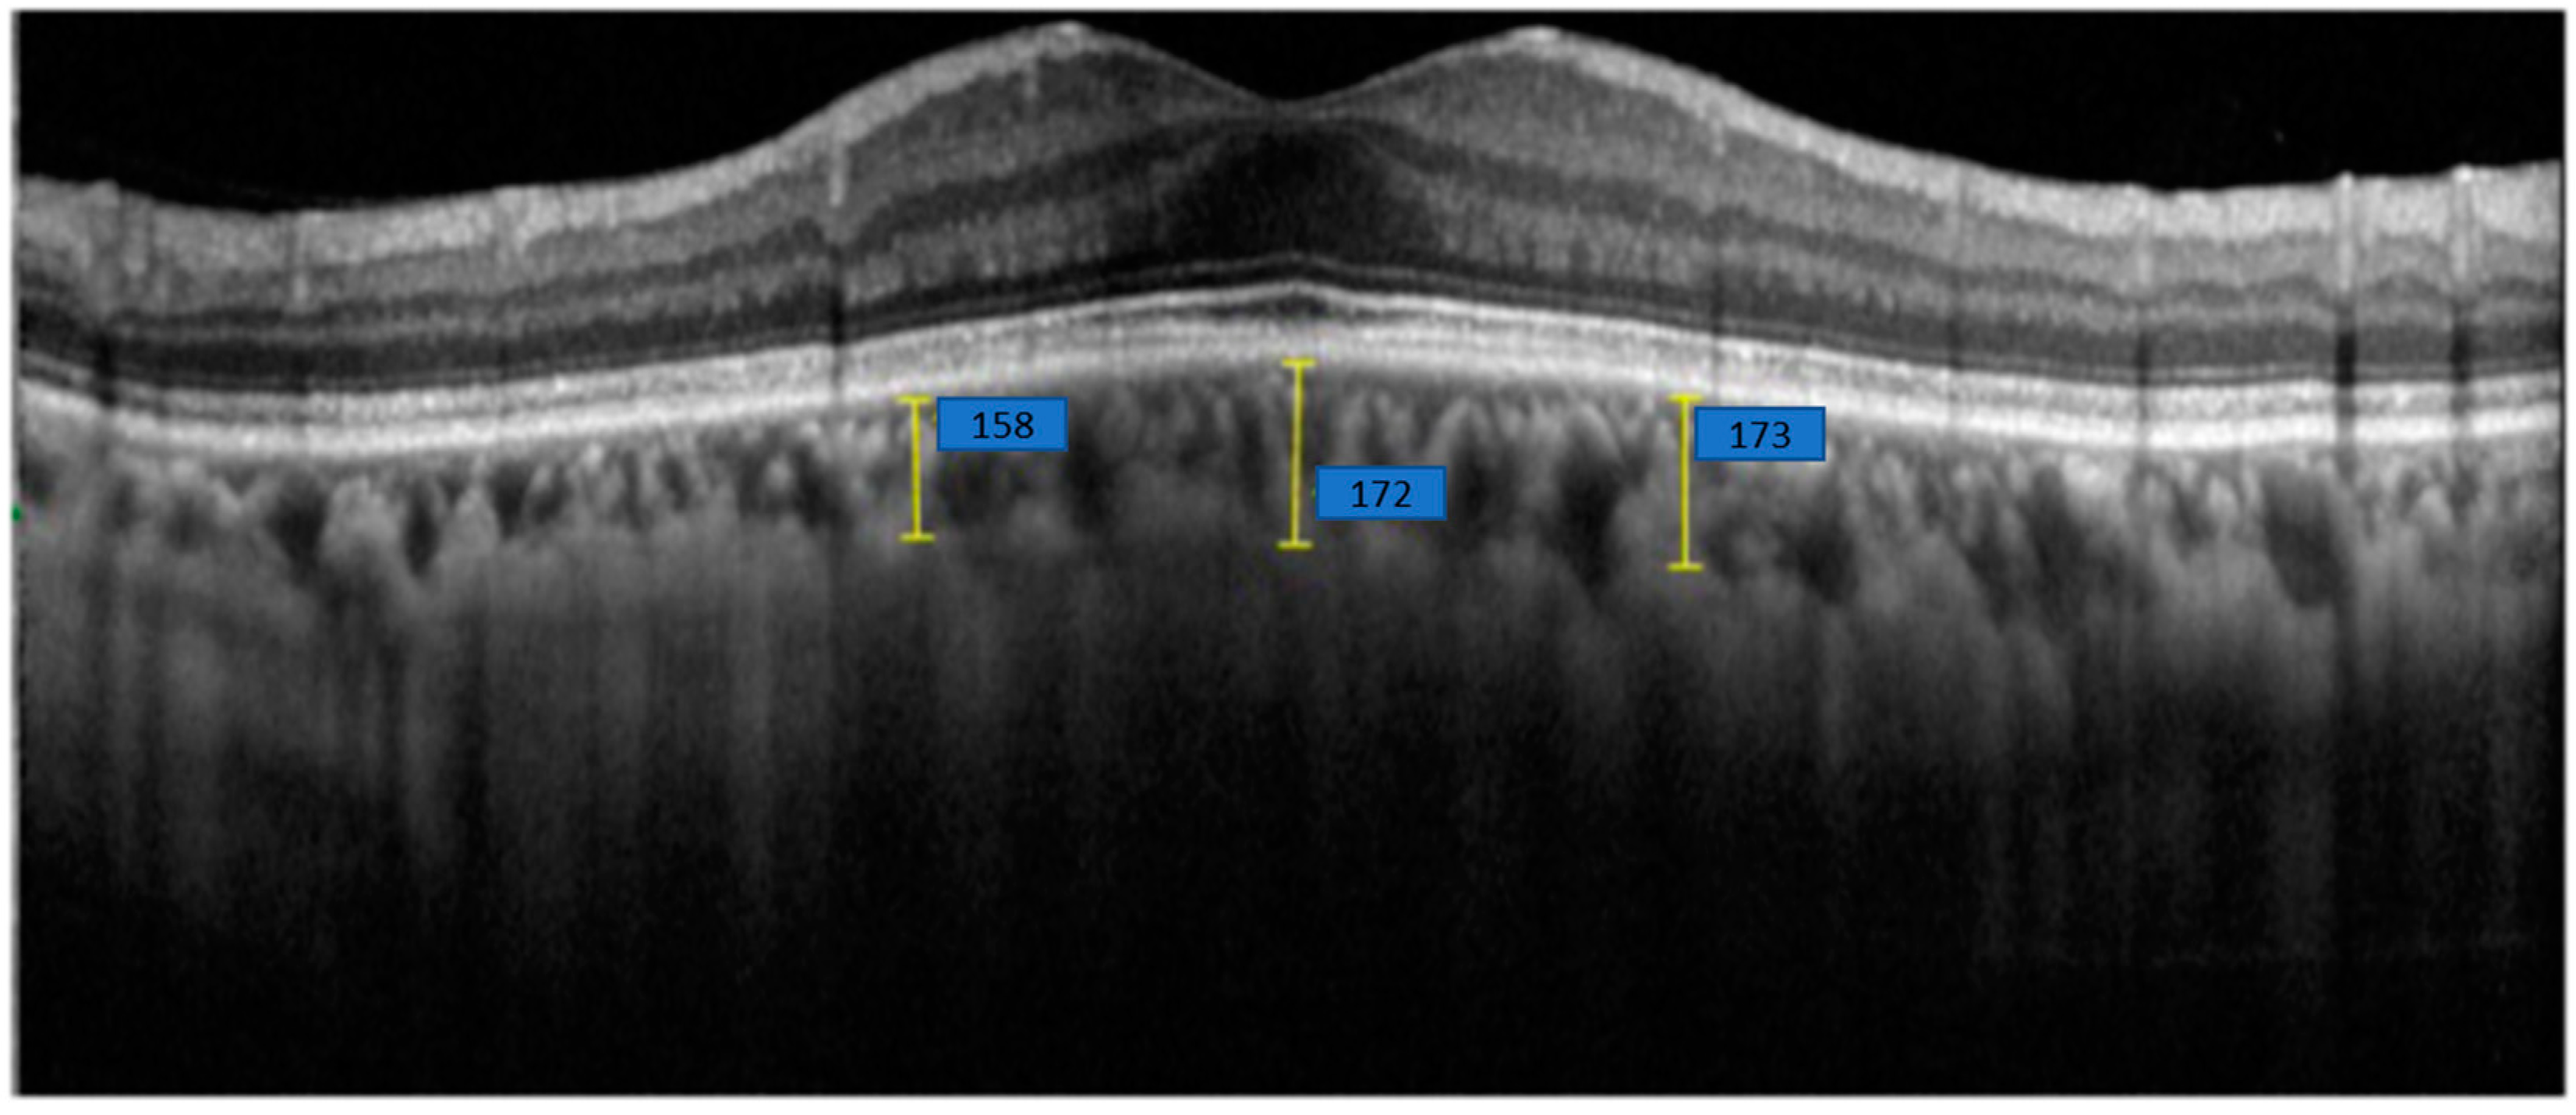
Optics 06 00012 g004

High-Myopia Diagnosis by Reciprocal of Circle Radius in Choroidal Image
Abstract
1. Introduction
2. Preliminary Knowledge
Myopia
- Low myopia: degree ≤ 300;
- Moderate: 300 < degree < 600;
- High myopia: 600 ≤ degree.
- Emmetropia: −0.5D < SPH ≤ 0.5D;
- Mild to moderate myopia: −6.00D < SPH ≤ −0.5D;
- High myopia: SPH ≤ −6.00D.
3. Method
3.1. Automatical Choroidal Segmentation and Thinning
3.2. Curvature Computation of a Small Segment on the Choroid Curve
3.3. Curvature of Patient’s Choroidal Curve
4. Experimental Results and Discussion
4.1. Description of Patient Data
4.1.1. Participants
4.1.2. Optical Coherence Tomography Machine and Scanning Settings
4.1.3. AXL Measurement
4.1.4. Features
4.2. Oversampling for Imbalanced Data
4.3. Results, Discussion, and Limitations
5. Conclusions
Author Contributions
Funding
Institutional Review Board Statement
Data Availability Statement
Conflicts of Interest
References
- Morgan, I.G.; Ohno-Matsui, K.; Saw, S.M. Myopia. Lancet 2012, 379, 1739–1748. [Google Scholar] [PubMed]
- Meng, W.; Butterworth, J.; Malecaze, F.; Calvas, P. Axial Length of Myopia: A Review of Current Research. Ophthalmologica 2011, 225, 127–134. [Google Scholar] [CrossRef] [PubMed]
- Flitcroft, D. The complex interactions of retinal, optical and environmental factors in myopia aetiology. Prog. Retin. Eye Res. 2012, 31, 622–660. [Google Scholar] [CrossRef] [PubMed]
- Tideman, J.W.L.; Snabel, M.C.C.; Tedja, M.S.; van Rijn, G.A.; Wong, K.T.; Kuijpers, R.W.A.M.; Vingerling, J.R.; Hofman, A.; Buitendijk, G.H.S.; Keunen, J.E.E.; et al. Association of Axial Length With Risk of Uncorrectable Visual Impairment for Europeans With Myopia. JAMA Ophthalmol. 2016, 134, 1355–1363. [Google Scholar] [CrossRef] [PubMed]
- Ikuno, Y. Overview of the complications of high myopia. Retina 2017, 37, 2347–2351. [Google Scholar] [CrossRef] [PubMed]
- Holden, B.A.; Fricke, T.R.; Wilson, D.A.; Jong, M.; Naidoo, K.S.; Sankaridurg, P.; Wong, T.Y.; Naduvilath, T.; Resnikoff, S. Global Prevalence of Myopia and High Myopia and Temporal Trends from 2000 through 2050. Ophthalmology 2016, 123, 1036–1042. [Google Scholar] [CrossRef] [PubMed]
- Zi, Y.; Deng, Y.; Zhao, J.; Ji, M.; Qin, Y.; Deng, T.; Jin, M. Morphologic and biochemical changes in the retina and sclera induced by form deprivation high myopia in guinea pigs. BMC Ophthalmol. 2020, 20, 105. [Google Scholar] [CrossRef]
- Waldstein, S.M.; Faatz, H.; Szimacsek, M.; Glodan, A.-M.; Podkowinski, D.; Montuoro, A.; Simader, C.; Gerendas, B.S.; Schmidt-Erfurth, U. Comparison of penetration depth in choroidal imaging using swept source vs spectral domain optical coherence tomography. Eye 2015, 29, 409–415. [Google Scholar] [CrossRef] [PubMed]
- Bartol-Puyal, F.D.A.; Isanta, C.; Ruiz-Moreno, O.; Abadia, B.; Calvo, P.; Pablo, L. Distribution of Choroidal Thinning in High Myopia, Diabetes Mellitus, and Aging: A Swept-Source OCT Study. J. Ophthalmol. 2019, 2019, 3567813. [Google Scholar] [PubMed]
- Wang, S.; Wang, Y.; Gao, X.; Qian, N.; Zhuo, Y. Choroidal thickness and high myopia: A cross-sectional study and meta-analysis. BMC Ophthalmol. 2015, 15, 70. [Google Scholar] [CrossRef] [PubMed]
- Park, U.C.; Ma, D.J.; Ghim, W.H.; Yu, H.G. Influence of the foveal curvature on myopic macular complications. Sci. Rep. 2019, 9, 16936. [Google Scholar] [CrossRef]
- Haarman, A.E.G.; Enthoven, C.A.; Tideman, J.W.L.; Tedja, M.S.; Verhoeven, V.J.M.; Klaver, C.C.W. The Complications of Myopia: A Review and Meta-Analysis. Investig. Ophthalmol. Vis. Sci. 2020, 61, 49. [Google Scholar] [CrossRef]
- Lu, H.-C.; Chen, H.-Y.; Huang, C.-J.; Chu, P.-H.; Wu, L.-S.; Tsai, C.-Y. Predicting Axial Length From Choroidal Thickness on Optical Coherence Tomography Images With Machine Learning Based Algorithms. Front. Med. 2022, 9, 850284. [Google Scholar] [CrossRef]
- Saw, S.; Gazzard, G.; Shih-Yen, E.C.; Chua, W. Myopia and associated pathological complications. Ophthalmic Physiol. Opt. 2005, 25, 381–391. [Google Scholar] [CrossRef] [PubMed]
- Flores-Moreno, I.; Lugo, F.; Duker, J.S.; Ruiz-Moreno, J.M. The Relationship Between Axial Length and Choroidal Thickness in Eyes With High Myopia. Arch. Ophthalmol. 2013, 155, 314–319.e1. [Google Scholar] [CrossRef]
- Wong, Y.L.; Sabanayagam, C.; Ding, Y.; Wong, C.-W.; Yeo, A.C.-H.; Cheung, Y.-B.; Cheung, G.; Chia, A.; Ohno-Matsui, K.; Wong, T.-Y.; et al. Prevalence, risk factors, and impact of myopic macular degeneration on visual im-pairment and functioning among adults in Singapore. Investig. Ophthalmol. Vis. Sci. 2018, 59, 4603–4613. [Google Scholar]
- Choudhury, F.; Meuer, S.M.; Klein, R.; Wang, D.; Torres, M.; Jiang, X.; McKean-Cowdin, R.; Varma, R.; Azen, S.P.; Hsu, C.; et al. Prevalence and Characteristics of Myopic Degeneration in an Adult Chinese American Population: The Chinese American Eye Study. Arch. Ophthalmol. 2018, 187, 34–42. [Google Scholar] [CrossRef]
- Naidoo, K.S.; Fricke, T.R.; Frick, K.D.; Jong, M.; Naduvilath, T.J.; Resnikoff, S.; Sankaridurg, P. Potential lost productivity resulting from the global burden of myopia: Systematic review, meta-analysis, and modeling. Ophthalmology 2019, 126, 338–346. [Google Scholar] [PubMed]
- Flitcroft, D.I.; He, M.; Jonas, J.B.; Jong, M.; Naidoo, K.; Ohno-Matsui, K.; Rahi, J.; Resnikoff, S.; Vitale, S.; Yannuzzi, L. IMI—Defining and Classifying Myopia: A Proposed Set of Standards for Clinical and Epidemiologic Studies. Investig. Ophthalmol. Vis. Sci. 2019, 60, M20–M30. [Google Scholar] [CrossRef] [PubMed]
- Chawla, N.V.; Bowyer, K.W.; Hall, L.O.; Kegelmeyer, W.P. SMOTE: Synthetic Minority Over-sampling Technique. J. Artif. Intell. Res. 2002, 16, 321–357. [Google Scholar] [CrossRef]
- Torgo, L.; Ribeiro, R.P.; Pfahringer, B.; Branco, P. SMOTE for Regression. In Progress in Artificial Intelligence; Lecture Notes in Computer Science; Springer: Berlin/Heidelberg, Germany, 2013; Volume 8154, pp. 378–389. [Google Scholar]
- He, H.; Bai, Y.; Garcia, E.A.; Li, S. ADASYN: Adaptive synthetic sampling approach for imbalanced learning. In Proceedings of the 2008 IEEE International Joint Conference on Neural Networks (IEEE World Congress on Computational Intelligence), Hong Kong, 1–8 June 2008; pp. 1322–1328. [Google Scholar]

| Mean | Number (%) |
|---|---|
| Non-high myopia, SPH > −6.00D | 282 (79.2%) |
| High myopia, SPH ≤ −6.00D | 74 (20.8%) |
| Non-high myopia, AXL ≤ 26 mm | 282 (79.2%) |
| High myopia, AXL > 26 mm | 74 (20.8%) |
| Oversampling Method | The Proposed Maximal Curvature Method | The Proposed Average Curvature Method |
|---|---|---|
| ROS | 25 | 26 |
| SMOTE | 27 | 32 |
| ADASYN | 27 | 31 |
| Oversampling Method | Accuracy of the Method [13] | Accuracy of the Proposed Maximal Curvature Method | Accuracy of the Proposed Average Curvature Method |
|---|---|---|---|
| ROS | 94.1% | 91.2% | 90.8% |
| SMOTE | 92.6% | 90.4% | 88.7% |
| ADASYN | 93.2% | 90.4% | 89.2% |
Disclaimer/Publisher’s Note: The statements, opinions and data contained in all publications are solely those of the individual author(s) and contributor(s) and not of MDPI and/or the editor(s). MDPI and/or the editor(s) disclaim responsibility for any injury to people or property resulting from any ideas, methods, instructions or products referred to in the content. |
© 2025 by the authors. Licensee MDPI, Basel, Switzerland. This article is an open access article distributed under the terms and conditions of the Creative Commons Attribution (CC BY) license (https://creativecommons.org/licenses/by/4.0/).
Share and Cite
Chen, S.-T.; Ye, R.-J.; Chen, C.-F.; Chang, K.-Y.; Huang, Y.-H.; Tseng, S.-J.; Liu, J.-Q. High-Myopia Diagnosis by Reciprocal of Circle Radius in Choroidal Image. Optics 2025, 6, 12. https://doi.org/10.3390/opt6020012
Chen S-T, Ye R-J, Chen C-F, Chang K-Y, Huang Y-H, Tseng S-J, Liu J-Q. High-Myopia Diagnosis by Reciprocal of Circle Radius in Choroidal Image. Optics. 2025; 6(2):12. https://doi.org/10.3390/opt6020012
Chicago/Turabian StyleChen, Shuo-Tsung, Ren-Jie Ye, Ching-Fu Chen, Keng-Yuan Chang, Yu-Hung Huang, Sheng-Jie Tseng, and Jun-Qi Liu. 2025. "High-Myopia Diagnosis by Reciprocal of Circle Radius in Choroidal Image" Optics 6, no. 2: 12. https://doi.org/10.3390/opt6020012
APA StyleChen, S.-T., Ye, R.-J., Chen, C.-F., Chang, K.-Y., Huang, Y.-H., Tseng, S.-J., & Liu, J.-Q. (2025). High-Myopia Diagnosis by Reciprocal of Circle Radius in Choroidal Image. Optics, 6(2), 12. https://doi.org/10.3390/opt6020012
